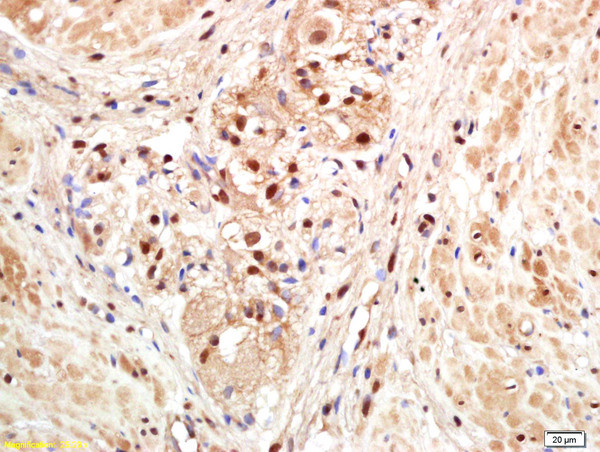
PAPOG Antibody in Immunohistochemistry (Paraffin) (IHC (P))

Search
Bioss
PAPOG Polyclonal Antibody
{{$productOrderCtrl.translations['antibody.pdp.commerceCard.promotion.promotions']}}
{{$productOrderCtrl.translations['antibody.pdp.commerceCard.promotion.viewpromo']}}
{{$productOrderCtrl.translations['antibody.pdp.commerceCard.promotion.promocode']}}: {{promo.promoCode}} {{promo.promoTitle}} {{promo.promoDescription}}. {{$productOrderCtrl.translations['antibody.pdp.commerceCard.promotion.learnmore']}}
产品信息
BS-4968R
种属反应
宿主/亚型
分类
类型
抗原
偶联物
形式
浓度
规格
纯化类型
保存液
内含物
保存条件
运输条件
靶标信息
This gene overlaps with the gene for cysteineendopeptidase AUT-like 4 in a head-to-tail orientation.
仅用于科研。不用于诊断过程。未经明确授权不得转售。
篇参考文献 (0)
生物信息学
蛋白别名: FLJ11805; FLJ12972; FLJ13482; FLJ14187; MGC133307; MGC133308; Neo-PAP; Neo-poly(A) polymerase; nuclear poly(A) polymerase gamma; nucleotidyl transferase; PAP-gamma; Poly(A) polymerase gamma; Polynucleotide adenylyltransferase gamma; Signal recognition particle RNA-adenylating enzyme; SRP 3'-adenylating protein; SRP RNA 3' adenylating enzyme/pap2; SRP RNA 3'-adenylating enzyme; SRP RNA-adenylating enzyme; unnamed protein product
基因别名: 9630006B20Rik; PAP2; PAPG; PAPOLG
UniProt ID: (Human) Q9BWT3, (Mouse) Q6PCL9
Entrez Gene ID: (Human) 64895, (Mouse) 216578, (Rat) 305586